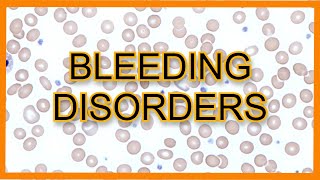
Bleeding Disorders (ITP vs TTP vs HUS vs DIC) || USMLE

Song info
"Bleeding"
(2007)
Sáng tác bởi LARA, NIL.
Sản xuất bởi Lyrics © Peermusic Publishing, Warner/Chappell Music, Inc..
0 người yêu thích
"Bleeding" Videos
Lyrics
They want you so very bad, it's glooming for miles
And the boys are talking about it all the while
And down like from totally far down they see you tweaking
And your lips are shivering, your secret story is leaking
You don't turn on the lights, dont talk on the phone
You hope that for at least a day, they'd leave you alone
And down like from totally far down they see you tweaking
And your lips are shivering, your secret story is leaking
Kicking and screaming, bleeding, becoming what you detest
Is what your proceeding
- 0 Bản dịch
Hiện tại chưa có lời dịch cho bài hát này. Bạn hãy là người đầu tiên chia sẻ lời dịch cho bài hát này nhé !
Đăng lời dịchAlbums has song "Bleeding"

Singles
22 songs
- Bleeding #2 2007
- Watch Out 2007
- Summer Of Overload 2007
- 9-5 2007
- Confusion Bay 2007
- Crack Of Dawn 2007
- Drive 2007
- From Out Of Nowhere 2007
- Bleeding 2007
- I Get What I See 2007
- Insane 2007
- Join The Scene 2007
- Leech 2007
- Morning Rise And A Friday Night 2007
- My Game 2007
- Never Be 2007
- Out Of Sight 2007
- The Devil 2007
- Abandon Your Hope 2006
- Twelve Feet Tall 2007
- Tonight 2007
- This Is Not An Exit 2007

Singles
22 songs
- Bleeding #2 2007
- Watch Out 2007
- Summer Of Overload 2007
- 9-5 2007
- Confusion Bay 2007
- Crack Of Dawn 2007
- Drive 2007
- From Out Of Nowhere 2007
- Bleeding 2007
- I Get What I See 2007
- Insane 2007
- Join The Scene 2007
- Leech 2007
- Morning Rise And A Friday Night 2007
- My Game 2007
- Never Be 2007
- Out Of Sight 2007
- The Devil 2007
- Abandon Your Hope 2006
- Twelve Feet Tall 2007
- Tonight 2007
- This Is Not An Exit 2007

Recent comments